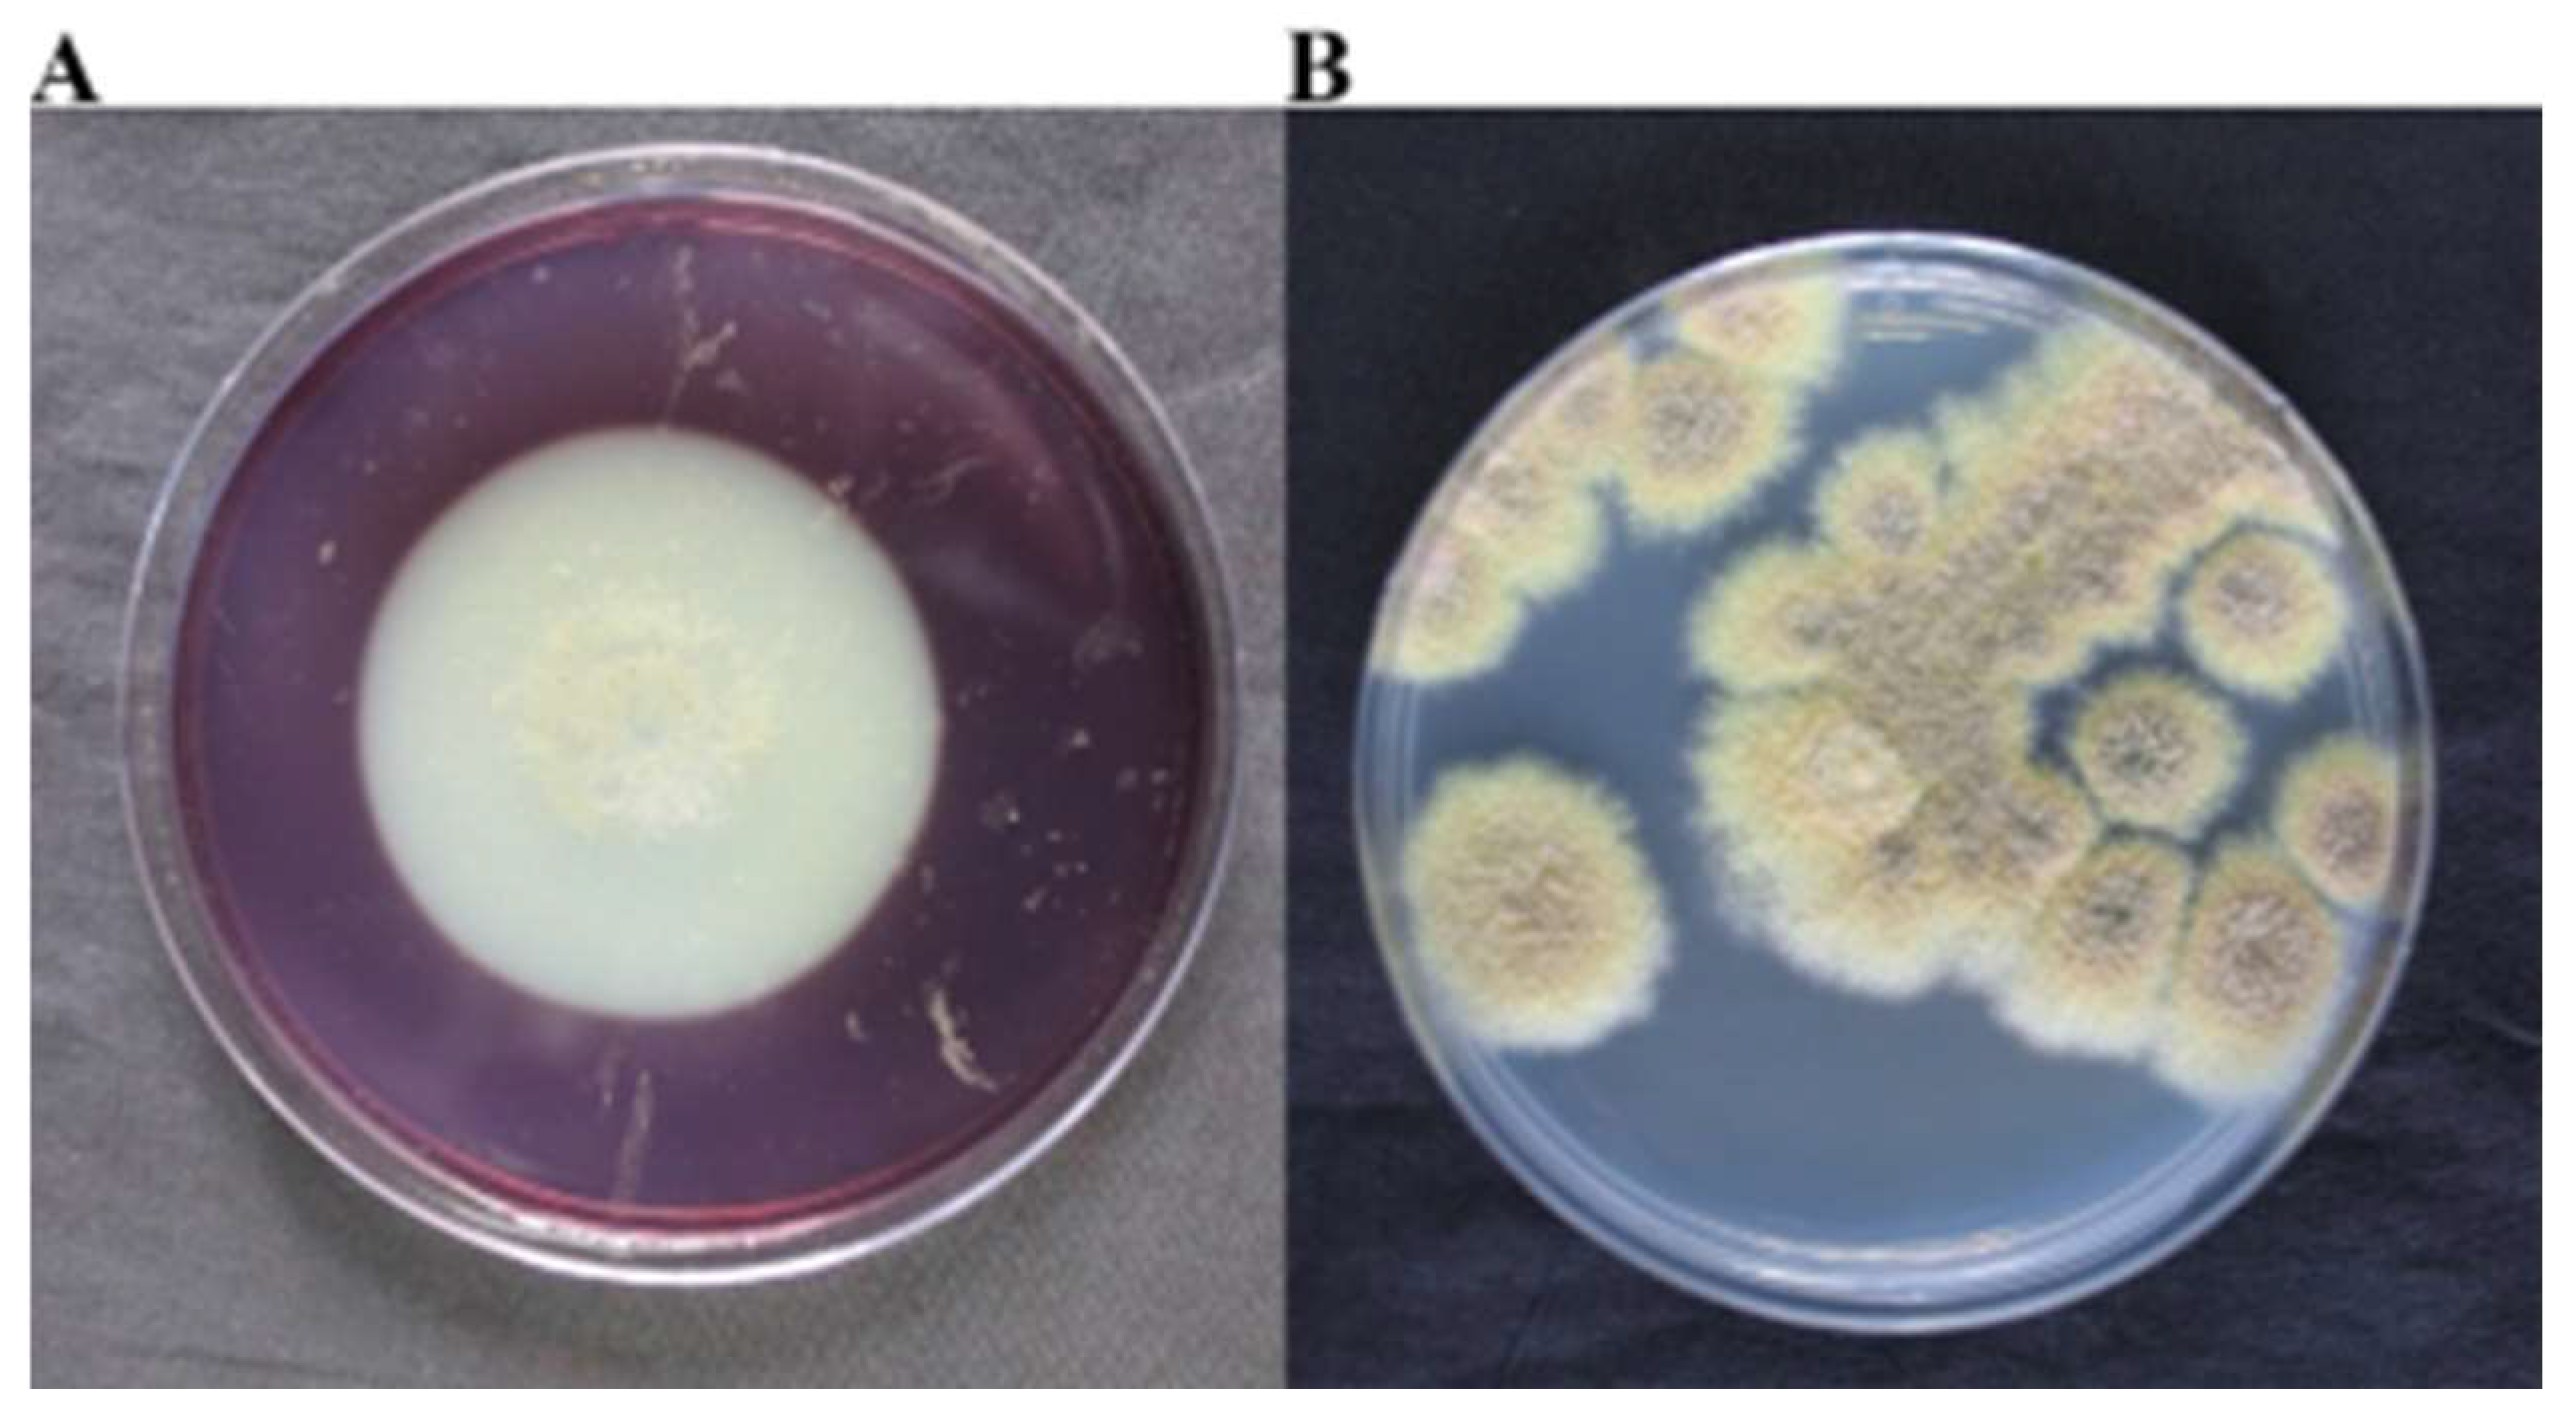
Ijms 25 12270 g005
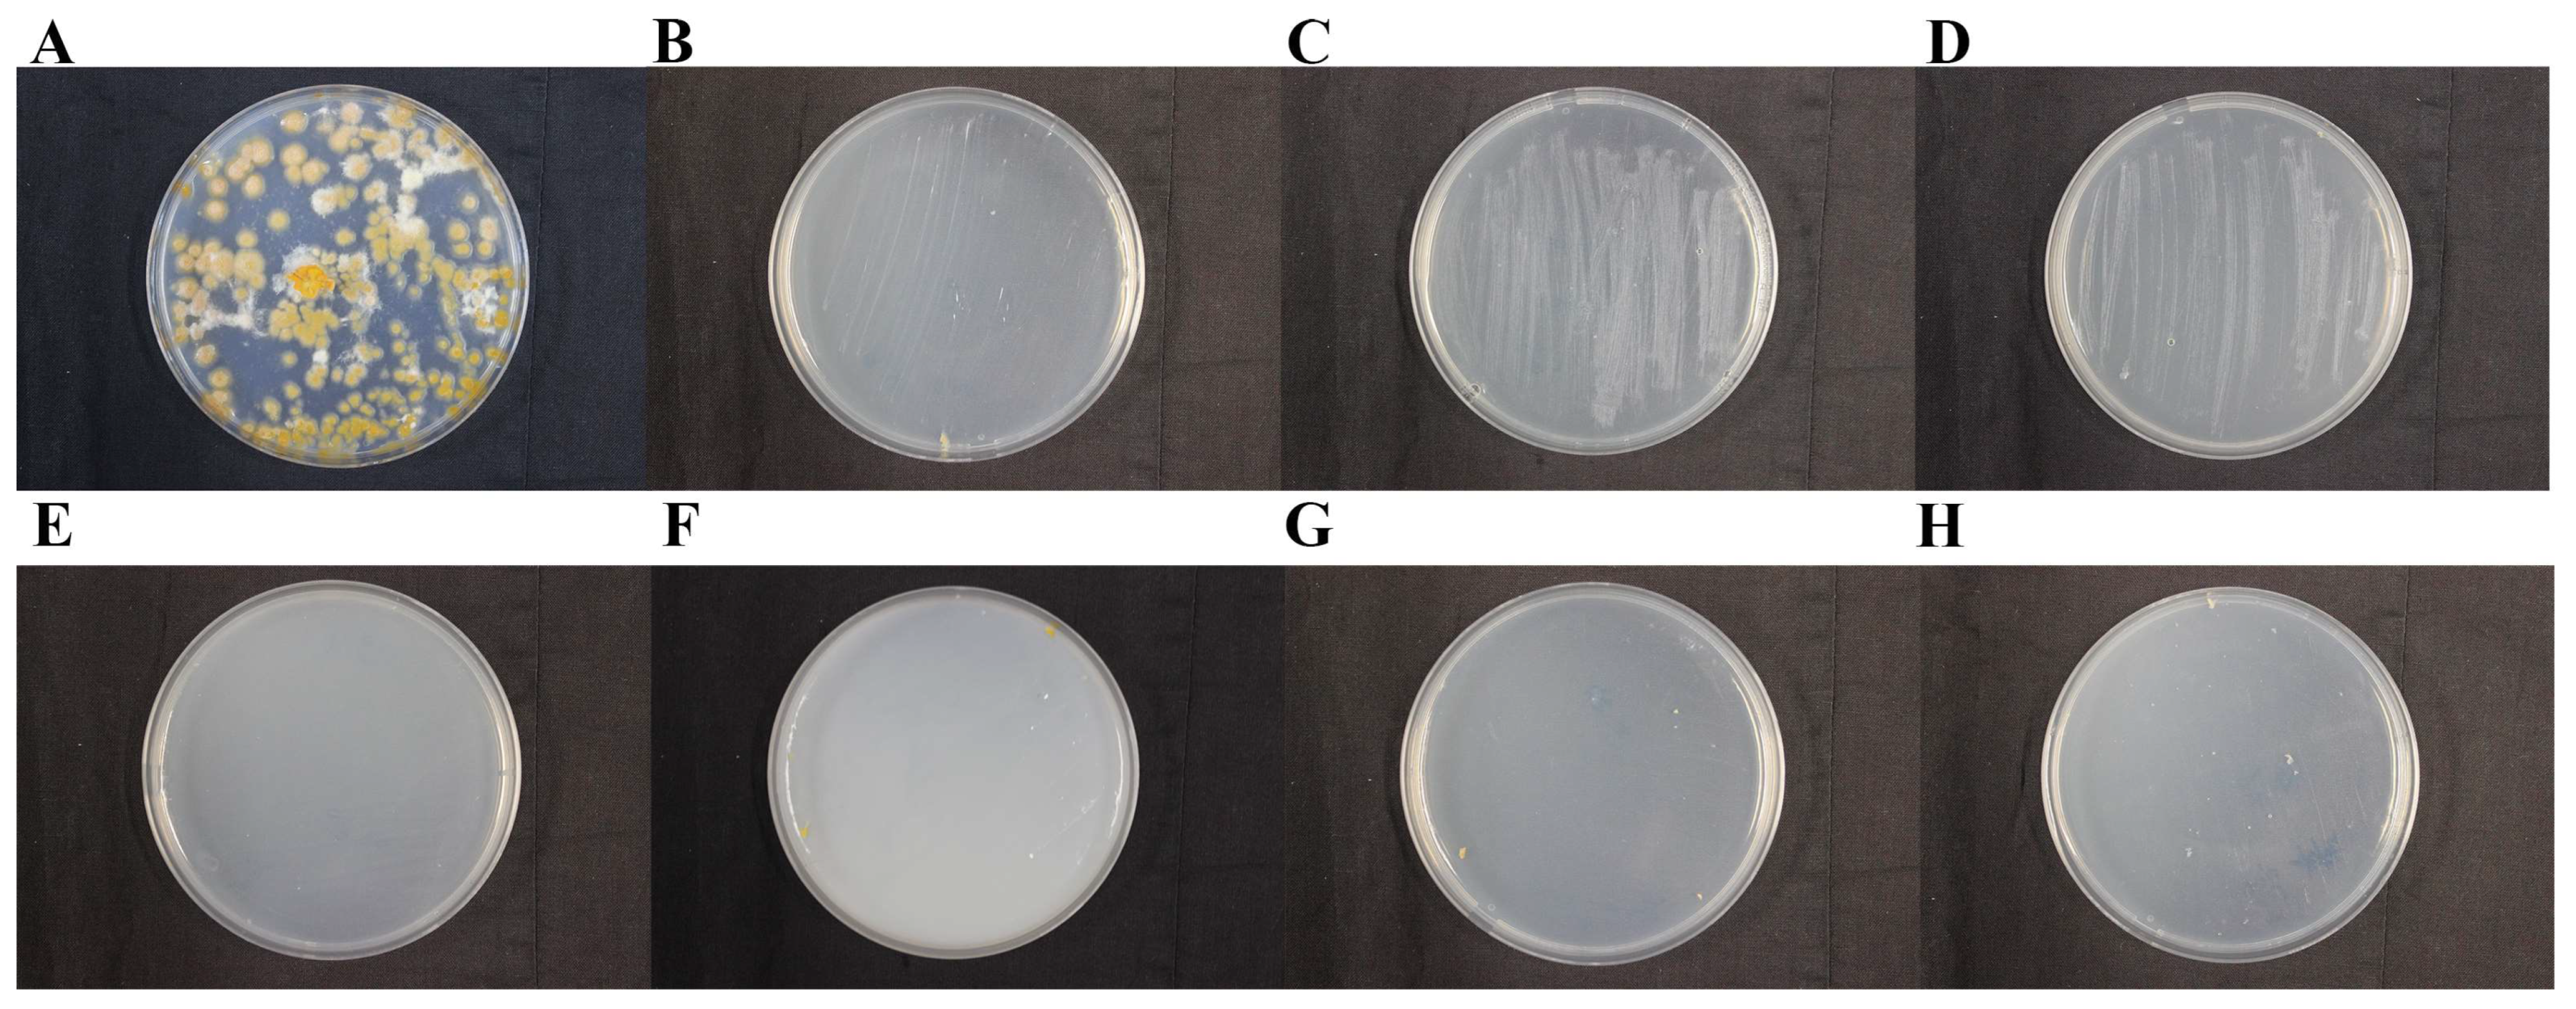
Ijms 25 12270 g007

Microbial Diversity and Biodegradation Mechanism of Microorganisms in the Dingtao M2 Tomb
Abstract
1. Introduction
2. Results
2.1. Scanning Electron Microscope (SEM) Results of Surface Samples of the M2 Tomb
2.2. Microbial Composition on the Surface and Surrounding Environment of the M2 Tomb
2.3. Database Annotation
2.4. Isolation, Purification, and Colony Morphology of Predominant Fungi
2.5. Determination of Cellulose Lignin Degradation Capability of Predominant Fungi
2.6. Effect of Various Conditions on Enzyme Activity of Dacrymyces
2.7. Sensitivity of Dominant Fungi to Different Fungicides
3. Discussion
4. Materials and Methods
4.1. Sample Collection and Microbial Investigation
4.2. SEM Observation
4.3. Metabolome Analysis
4.4. Metagenomic Sequencing Analysis
4.5. X-ray Fluorescence
4.6. X-ray Diffraction
4.7. Detection of Fungal Cellulose Lignin Degradation Capability
4.8. Detection of Cellulose and Lignin Degrading Enzymes
4.9. Optimization of the Growth Conditions
4.10. Fungicidal Experiment
5. Conclusions
Supplementary Materials
Author Contributions
Funding
Institutional Review Board Statement
Informed Consent Statement
Data Availability Statement
Acknowledgments
Conflicts of Interest
References
- Wu, Q.; Zhang, B.; Hu, Y. Comparison and research progress of protein detection technology for cultural relic materials. Coatings 2023, 13, 1319. [Google Scholar] [CrossRef]
- Zhou, Q.; Yan, W. Oscillation response of museum cultural relics under earthquake by shaking table tests. Appl. Mech. Mater. 2011, 105–107, 392–397. [Google Scholar] [CrossRef]
- Pruvost, M.; Bellone, R.; Benecke, N.; Sandoval-Castellanos, E.; Cieslak, M.; Kuznetsova, T.; Morales-Muñiz, A.; O’Connor, T.; Reissmann, M.; Hofreiter, M.; et al. Genotypes of predomestic horses match phenotypes painted in Paleolithic works of cave art. Proc. Natl. Acad. Sci. USA 2011, 108, 18626–18630. [Google Scholar] [CrossRef]
- Sterflinger, K.; Pinzari, F. The revenge of time: Fungal deterioration of cultural heritage with particular reference to books, paper and parchment. Environ. Microbiol. 2012, 14, 559–566. [Google Scholar] [CrossRef]
- Sterflinger, K.; Piñar, G. Microbial deterioration of cultural heritage and works of art—Tilting at windmills? Appl. Microbiol. Biotechnol. 2013, 97, 9637–9646. [Google Scholar] [CrossRef] [PubMed]
- Piñar, G.; Sterflinger, K.; Pinzari, F. Unmasking the measles-like parchment discoloration: Molecular and microanalytical approach. Environ. Microbiol. 2015, 17, 427–443. [Google Scholar] [CrossRef]
- Kakakhel, M.A.; Wu, F.; Gu, J.; Feng, H.; Shah, K.; Wang, W. Controlling biodeterioration of cultural heritage objects with biocides: A review. Int. Biodeterior. Biodegrad. 2019, 143, 104721. [Google Scholar] [CrossRef]
- Farooq, M.; Hassan, M.; Gull, F. Mycobial deterioration of stone monuments of Dharmarajika, Taxila. J. Microbiol. Exp. 2015, 2, 29–33. [Google Scholar] [CrossRef]
- Meng, H.; Katayama, Y.; Gu, J. More wide occurrence and dominance of ammonia-oxidizing oarchaea than bacteria at three Angkor sandstone temples of Bayon, Phnom Krom and Wat Athvea in Cambodia. Int. Biodeterior. Biodegrad. 2017, 117, 78–88. [Google Scholar] [CrossRef]
- Elam, J.; Björdal, C.G. Degradation of wood buried in soils exposed to artificially lowered groundwater levels in a laboratory setting. Int. Biodeterior. Biodegrad. 2022, 176, 105522. [Google Scholar] [CrossRef]
- Pearsall, D.M. Paleoethnobotany: A Handbook of Procedures; Left Coast Press: Walnut Creek, CA, USA, 2015. [Google Scholar]
- Beccaccioli, M.; Moricca, C.; Faino, L.; Reale, R.; Mineo, M.; Reverberi, M. The Neolithic site La Marmotta: DNA metabarcoding to identify the microbial deterioration of waterlogged archeological wood. Front. Microbiol. 2023, 14, 1129983. [Google Scholar] [CrossRef] [PubMed]
- Liu, Z.; Fu, T.; Hu, C.; Shen, D.; Macchioni, N.; Sozzi, L.; Chen, Y.; Liu, J.; Tian, X.; Ge, Q.; et al. Microbial community analysis and biodeterioration of waterlogged archaeological wood from the Nanhai No. 1 shipwreck during storage. Sci. Rep. 2018, 8, 7170. [Google Scholar] [CrossRef] [PubMed]
- Björdal, C.G.; Nilsson, T.; Daniel, G. Microbial decay of waterlogged archaeological wood found in Sweden Applicable to archaeology and conservation. Int. Biodeterior. Biodegrad. 1999, 43, 63–73. [Google Scholar] [CrossRef]
- Capretti, C.; Macchioni, N.; Pizzo, B.; Galotta, G.; Giachi, G.; Giampaola, D. The characterization of waterlogged archaeological wood: The three roman ships found in Naples (Italy). Archaeometry 2008, 50, 855–876. [Google Scholar] [CrossRef]
- Schwarze, F. Wood decay under the microscope. Fungal Biol. Rev. 2007, 21, 133–170. [Google Scholar] [CrossRef]
- Björdal, C.G. Microbial degradation of waterlogged archaeological wood. J. Cult. Herit. 2012, 13, S118–S122. [Google Scholar] [CrossRef]
- Rytioja, J.; Hildén, K.; Yuzon, J.; Hatakka, A.; Vries, R.P.; Mäkelä, M.R. Plant-polysaccharide-degrading enzymes from Basidiomycetes. Microbiol. Mol. Biol. Rev. 2014, 78, 614–649. [Google Scholar] [CrossRef]
- Medie, F.M.; Davies, G.J.; Drancourt, M.; Henrissat, B. Genome analyses highlight the different biological roles of cellulases. Nat. Rev. Microbiol. 2012, 10, 227–234. [Google Scholar] [CrossRef]
- Obeng, E.M.; Adam, S.N.N.; Budiman, C.; Ongkudon, C.M.; Maas, R.; Jose, J. Lignocellulases: A review of emerging and developing enzymes, systems, and practices. Bioresour. Bioprocess. 2017, 4, 16. [Google Scholar] [CrossRef]
- Xu, S.; Ma, Q.; Xu, S. Fuzzy comprehensive evaluation of the compatibility of restoration materials—Case study in the rammed earth restoration of the M2 Han tomb in Dingtao, Shandong Province. J. Cult. Herit. 2022, 57, 131–141. [Google Scholar] [CrossRef]
- Liu, Z.; Wang, Y.; Pan, X.; Ge, Q.; Ma, Q.; Li, Q.; Fu, T.; Hu, C.; Zhu, X.; Pan, J. Identification of fungal communities associated with the biodeterioration of waterlogged archeological wood in a Han dynasty tomb in China. Front. Microbiol. 2017, 8, 1633. [Google Scholar] [CrossRef] [PubMed]
- Han, Y.; Huang, X.; Wang, Y.; Du, J.; Ma, K.; Chen, Y.; Li, N.; Zhang, Z.; Pan, J. Fungal community and biodeterioration analysis of hull wood and its storage environment of the Nanhai No. 1 shipwreck. Front. Microbiol. 2021, 11, 609475. [Google Scholar] [CrossRef] [PubMed]
- He, Y.; Li, W.; Lu, X.; Xu, C.; Jin, T.; Lin, G. Chinese export porcelain in the middle Qing Dynasty: Study on the blue-and-white porcelains excavated from the Xiaobaijiao I shipwreck. J. Archaeol. Sci. Rep. 2021, 38, 103024. [Google Scholar] [CrossRef]
- Rajala, T.; Peltoniemi, M.; Hantula, J.; Mäkipää, R.; Pennanen, T. RNA reveals a succession of active fungi during decay of Norway spruce logs. Fungal Ecol. 2011, 4, 437–448. [Google Scholar] [CrossRef]
- Bani, A.; Pioli, S.; Ventura, M.; Panzacchi, P.; Borruso, L.; Tognetti, R.; Tonon, G.; Brusetti, L. The role of microbial community in the decomposition of leaf litter and deadwood. Appl. Soil Ecol. 2018, 126, 75–84. [Google Scholar] [CrossRef]
- Gómez-Brandón, M.; Probst, M.; Siles, J.A.; Peintner, U.; Bardelli, T.; Egli, M.; Insam, H.; Ascher-Jenull, J. Fungal communities and their association with nitrogen-fixing bacteria affect early decomposition of Norway spruce deadwood. Sci. Rep. 2020, 10, 8025. [Google Scholar] [CrossRef]
- Sun, J.; Ruan, Y.; Jin, S.; Wang, L. The importance of Talaromyces and its taxonomic studies. J. Fungal Res. 2021, 19, 83–93. [Google Scholar] [CrossRef]
- Nagy, L.G.; Riley, R.; Tritt, A.; Adam, C.; Daum, C.; Floudas, D.; Sun, H.; Yadav, J.S.; Pangilinan, J.; Larsson, K.H.; et al. Comparative genomics of early-diverging mushroom-forming fungi provides insights into the origins of lignocellulose decay capabilities. Mol. Biol. Evol. 2015, 33, 959–970. [Google Scholar] [CrossRef]
- Floudas, D.; Binder, M.; Riley, R.; Barry, K.; Blanchette, R.A.; Henrissat, B.; Martínez, A.T.; Otillar, R.; Spatafora, J.W.; Yadav, J.S.; et al. The Paleozoic origin of enzymatic lignin decomposition reconstructed from 31 fungal genomes. Science 2012, 336, 1715–1719. [Google Scholar] [CrossRef]
- Fujii, T.; Hoshino, T.; Inoue, H.; Yano, S. Taxonomic revision of the cellulose degrading fungus Acremonium cellulolyticus nomen nudum to Talaromyces based on phylogenetic analysis. FEMS Microbiol. Lett. 2013, 351, 32–34. [Google Scholar] [CrossRef]
- Houbraken, J.; Spierenburg, H.; Frisvad, J.C. Rasamsonia, a new genus comprising thermotolerant and thermophilic Talaromyces and Geosmithia species. Antonie Van Leeuwenhoek 2012, 101, 403–421. [Google Scholar] [CrossRef] [PubMed]
- Pol, D.; Laxman, S.; Rao, M. Purification and biochemical characterization of endoglucanase from Penicillium pinophilum MS 20. Indian J. Biochem. Biophys. 2012, 49, 189–194. [Google Scholar] [PubMed]
- Maeda, R.N.; Barcelos, C.A.; Anna, L.M.M.; Pereira, N., Jr. Cellulase production by Penicillium funiculosum and its application in the hydrolysis of sugar cane bagasse for second generation ethanol production by fed batch operation. J. Biotechnol. 2013, 163, 38–44. [Google Scholar] [CrossRef]
- Morozova, V.V.; Gusakov, A.; Andrianov, R.M.; Pravilnikov, A.G. Cellulases of Penicillium verruculosum. Biotechnol. J. 2010, 5, 871–880. [Google Scholar] [CrossRef]
- Goyari, S.; Devi, S.H.; Bengyella, L.; Khan, M.; Sharma, C.K.; Kalita, M.C.; Talukdar, N.C. Unveiling the optimal parameters for cellulolytic characteristics of Talaromyces verruculosus SGMNPf3 and its secretory enzymes. J. Appl. Microbiol. 2015, 119, 88–98. [Google Scholar] [CrossRef] [PubMed]
- Romdhane, I.B.B.; Achouri, I.M.; Belghith, H. Improvement of highly thermostable xylanases production by Talaromyces thermophilus for the agro-industrials residue hydrolysis. Appl. Biochem. Biotechnol. 2010, 162, 1635–1646. [Google Scholar] [CrossRef]
- Liao, H.; Zheng, H.; Li, S.; Wei, Z.; Mei, X.; Ma, H.; Shen, Q.; Xu, Y. Functional diversity and properties of multiple xylanases from Penicillium oxalicum GZ-2. Sci. Rep. 2015, 5, 12631. [Google Scholar] [CrossRef]
- Yilmaz, N.; Houbraken, J.; Hoekstra, E.S.; Frisvad, J.C.; Visagie, C.M.; Samson, R.A. Delimitation and characterisation of Talaromyces purpurogenus and related species. Persoonia 2012, 29, 39–54. [Google Scholar] [CrossRef] [PubMed]
- Frisvad, J.C.; Yilmaz, N.; Thrane, U.; Rasmussen, K.B.; Houbraken, J.; Samson, R.A. Talaromyces atroroseus, a new species efficiently producing industrially relevant red pigments. PLoS ONE 2013, 8, e84102. [Google Scholar] [CrossRef]
- Bhatnagar, S.; Kobori, T.; Ganesh, D.; Aoyagi, H. Fungal pigment–assisted silver nanoparticle synthesis and their antimicrobial and cytotoxic potential. Plant Second. Metab. Eng. 2022, 2469, 65–78. [Google Scholar] [CrossRef]
- Lebeau, J.; Petit, T.; Fouillaud, M.; Dufossé, L.; Caro, Y. Alternative extraction and characterization of nitrogen-containing azaphilone red pigments and ergosterol derivatives from the marine-derived fungal Talaromyces sp. 30570 strain with industrial relevance. Microorganisms 2020, 8, 1920. [Google Scholar] [CrossRef] [PubMed]
- Blanchette, R.A. A review of microbial deterioration found in archaeological wood from different environments. Int. Biodeterior. Biodegrad. 2000, 46, 189–204. [Google Scholar] [CrossRef]
- Björdal, C.G.; Rönnby, J. Evaluation of in situ preservation method applied at a terrestrial archaeological shipwreck site by use of sacrificial wood samples installed for 25 years. Int. Biodeterior. Biodegrad. 2023, 176, 105528. [Google Scholar] [CrossRef]
- Antonelli, F.; Bartolini, M.; Plissonnier, M.L.; Esposito, A.; Galotta, G.; Ricci, S.; Davidde Petriaggi, B.; Pedone, C.; Di Giovanni, A.; Piazza, S.; et al. Essential oils as alternative biocides for the preservation of waterlogged archaeological wood. Microorganisms 2020, 8, 2015. [Google Scholar] [CrossRef]

| Enzyme | Maximum Enzyme Activity (U/mL) | Maximum Specific Enzyme Activity (U/mg) | Cultivation Time (Days) |
|---|---|---|---|
| MnP | 0.4958 | 0.2057 | 10 |
| Lip | 2.3225 | 0.9760 | 8 |
| Lac | 0.1778 | 0.0725 | 12 |
| Cellulase | 104.6331 | 42.6830 | 13 |
| Fungicide | Main Fungicidal Components | Concentration (m/v) |
|---|---|---|
| K100 | 0.75% Isothiazolinone | 0.5% |
| Miconazole Nitrate | Miconazole Nitrate | 5% |
| BC01 | 3% Isothiazolinone | 0.05%, 0.3% |
| BC08 | Quaternary ammonium salt, 1.02 g/mL | 0.5%, 3.5% |
| BC14 | 14% Isothiazolinone | 0.025%, 0.5% |
Disclaimer/Publisher’s Note: The statements, opinions and data contained in all publications are solely those of the individual author(s) and contributor(s) and not of MDPI and/or the editor(s). MDPI and/or the editor(s) disclaim responsibility for any injury to people or property resulting from any ideas, methods, instructions or products referred to in the content. |
© 2024 by the authors. Licensee MDPI, Basel, Switzerland. This article is an open access article distributed under the terms and conditions of the Creative Commons Attribution (CC BY) license (https://creativecommons.org/licenses/by/4.0/).
Share and Cite
Wang, Y.; Wang, C.; Hou, L.; Yang, X.; Li, C.; Cui, S.; Ma, C.; Wang, L.; Zhang, L.; Liu, Y.; et al. Microbial Diversity and Biodegradation Mechanism of Microorganisms in the Dingtao M2 Tomb. Int. J. Mol. Sci. 2024, 25, 12270. https://doi.org/10.3390/ijms252212270
Wang Y, Wang C, Hou L, Yang X, Li C, Cui S, Ma C, Wang L, Zhang L, Liu Y, et al. Microbial Diversity and Biodegradation Mechanism of Microorganisms in the Dingtao M2 Tomb. International Journal of Molecular Sciences. 2024; 25(22):12270. https://doi.org/10.3390/ijms252212270
Chicago/Turabian StyleWang, Yu, Cen Wang, Lilong Hou, Xinyu Yang, Chenghao Li, Shengkuan Cui, Cuilian Ma, Ling Wang, Lu Zhang, Yuanyuan Liu, and et al. 2024. "Microbial Diversity and Biodegradation Mechanism of Microorganisms in the Dingtao M2 Tomb" International Journal of Molecular Sciences 25, no. 22: 12270. https://doi.org/10.3390/ijms252212270
APA StyleWang, Y., Wang, C., Hou, L., Yang, X., Li, C., Cui, S., Ma, C., Wang, L., Zhang, L., Liu, Y., Guo, H., & Pan, J. (2024). Microbial Diversity and Biodegradation Mechanism of Microorganisms in the Dingtao M2 Tomb. International Journal of Molecular Sciences, 25(22), 12270. https://doi.org/10.3390/ijms252212270







